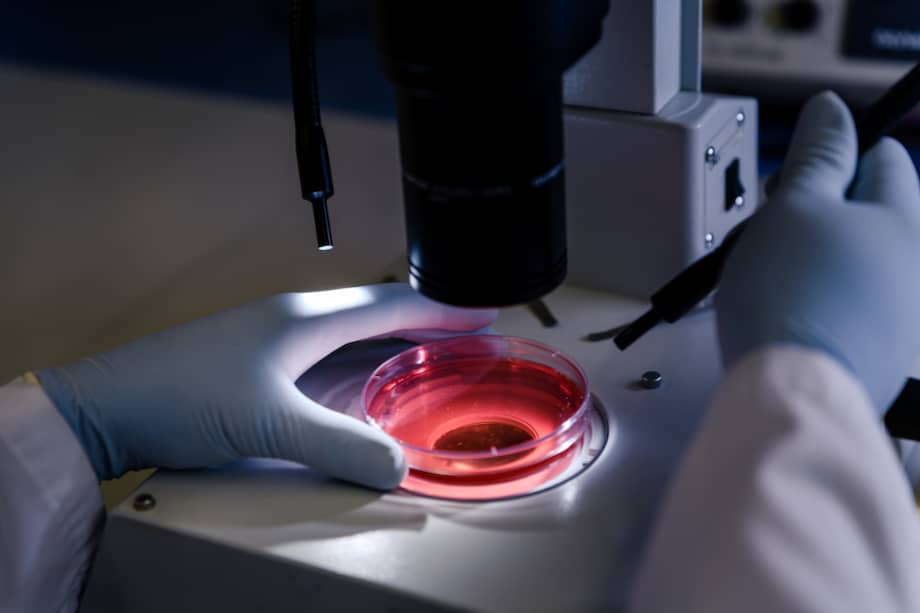
Una mayor atención a la prevención del cáncer reduciría el número de personas que lo desarrollan y, por tanto, permitiría disponer de más recursos para los que sí requieren tratamiento. Imagen de referencia.

Escucha este artículo
Audio generado con IA de Google
0:00
/
0:00
Un nuevo informe titulado European Groundshot - Addressing Europe’s Cancer Research Challenges: a Lancet Oncology Commission, reunió a un amplio abanico de pacientes, científicos y expertos sanitarios con un conocimiento detallado del cáncer en toda Europa.
El impacto del covid-19 y la atención que se le ha prestado ha puesto de manifiesto las debilidades de los sistemas sanitarios contra el cáncer y en el panorama de la investigación oncológica en todo el continente europeo. De acuerdo con expertos, si estos problemas no se abordan con urgencia, se dará un paso atrás en los hallazgos del cáncer de casi una década.
Le puede interesar: La población mundial superó los 8.000 millones de personas
Una de las consecuencias imprevistas de la pandemia fueron los efectos adversos que la rápida reconversión de los servicios sanitarios y los cierres nacionales, lo que terminó afectando los servicios oncológicos en la investigación sobre el cáncer y en los pacientes que padecen esta enfermedad.
“Para subrayar la magnitud de este problema, calculamos que durante la pandemia de covid-19 podrían haberse perdido alrededor de un millón de diagnósticos de cáncer en toda Europa”, escribieron en The Lancet Oncology. El informe también encontró que uno de cada dos pacientes con cáncer no recibió cirugía o quimioterapia a tiempo y que se dejaron de hacer unas 100 millones de pruebas de detección.
“Hay pruebas emergentes de que una mayor proporción de pacientes son diagnosticados con estadios de cáncer más avanzados en comparación con las tasas anteriores a la pandemia, como resultado de los retrasos sustanciales en el diagnóstico y el tratamiento del cáncer. Este cambio en el estadio del cáncer continuará presionando a los sistemas oncológicos europeos durante los próximos años”, agregó.
También puede leer: La concentración de esperma ha disminuido en más de un 50% en los últimos 40 años
El profesor de la Universidad Queen’s de Belfast Mark Lawler, autor principal del informe, señaló que Europa está en una carrera contrarreloj para encontrar los “cánceres perdidos”. Además, mostró su preocupación por la posibilidad de que el continente se dirija hacia una “epidemia de cáncer” en la próxima década si no se priorizan los sistemas sanitarios y la investigación sobre esta enfermedad.
En este aspecto, el informe señaló que la invasión de Rusia a Ucrania representa otro gran desafío en materia de investigación, pues los dos países son contribuyentes importantes en la investigación clínica del cáncer en el mundo.
“Con el telón de fondo de la pandemia de covid-19, el Brexit y la invasión rusa de Ucrania, es más importante que nunca que Europa desarrolle un panorama de investigación sobre el cáncer resistente para desempeñar un papel transformador en la mejora de la prevención, el diagnóstico, el tratamiento y la calidad de vida de los pacientes actuales y futuros y de los que viven más allá del cáncer”, dijo Lawler.
Le puede interesar: Estos son los principales objetivos de la misión que despegó hacia la Luna
Una mayor atención a la prevención del cáncer reduciría el número de personas que lo desarrollan y, por tanto, permitiría disponer de más recursos para los que sí requieren tratamiento, afirma el informe. De hecho, Anna Schmütz, de la Agencia Internacional para la Investigación del Cáncer, sostuvo que el 40% de los cánceres en Europa podrían evitarse si las estrategias de prevención primaria utilizaran mejor los conocimientos actuales sobre los factores de riesgo.
👩⚕️⚕️🩺 📄¿Quieres conocer las últimas noticias sobre salud? Te invitamos a verlas en El Espectador. 💉🩹🌡️